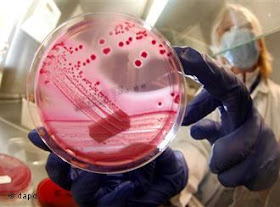

almanya türkiyeden gelen meyve sebzeleri ilaç oranı yüksek mazeretleriyle geri gönderiyordu şimdi ispanyadan gelen salatalıklarda ehec virüsü tespit etti.
Deutsche Welle'nin haberi
Kuzey Almanya'da ortaya çıkan ve kısa süre içinde hızla yayılan EHEC virüsüne yakalananların sayısı 600'e ulaştı. Aşağı Saksonya Eyaleti Sağlık Bakanlığı, dün hayatını kaybeden kişinin de büyük olasılıkla virüsten öldüğünü açıkladı.
Robert Koch Enstitüsü hastalardan 140'ının kanlı ishal ve böbrek rahatsızlığından muzdarip olduğunu, durumlarının ciddiyetini koruduğunu belirtti. Virüse şimdiye dek 14 eyalette rastlandı. Sadece Hamburg'da mide ve bağırsak enfeksiyonu nedeniyle hastanede tedavi görenlerin sayısı 59. Robert Koch Enstitüsü, hastaların çoğunun kadın olduğunu, bunun alışılmadık bir durum olduğunu kaydetti. Hastaların yaklaşık 70'i ise çocuk.
Virüsle ilgili incelemeler sürüyor
Bu arada EHEC virüsüyle ilgili araştırmalar tüm hızıyla sürüyor. Yetkililer yapılan araştırmaların virüsün sebzelerden bulaştığını gösterdiğine dikkat çekiyor. Hastaların büyük çoğunluğunun son günlerde ağırlıklı olarak domates, salatalık ve marul yediği tespit edildi. Bu nedenle özellikle Kuzey Almanya'da yetişen marul, domates ve salatalıklara dikkat edilmesi çağrısında bulunuldu. Yetkililer virüsün kaynağının gübre ya da kirli su olabileceğini belirtti. Hamburg'daki Hijyen Enstitüsü sadece Almanya'da yetişen değil, İspanya'dan getirilen salatalıklarda da EHEC virüsü tespit etti.
Federal Sağlık Bakanı Daniel Bahr, EHEC virüsünün yayılmasıyla mücadele için alınan önlemleri şimdilik yeterli bulduğunu söyledi. Bakan, virüsün yayılması ve uluslararası bir sorun haline gelmesi halinde, kriz masası oluşturulacağını da vurguladı.
Hiç yorum yok :
Write yorumNe düşündüğünüzü bize söyleyin ... !